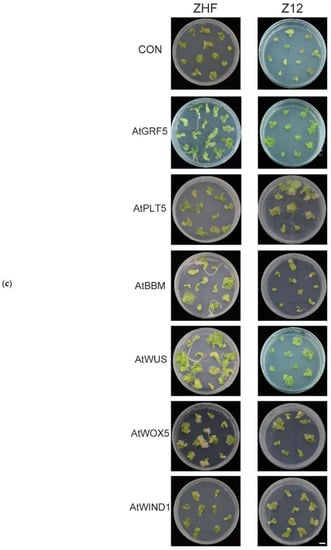

Abstract
Melon (Cucumis melo L.) is a protected crop in China with high economic value. Agrobacterium-mediated genetic transformation is a powerful tool to improve agronomic traits and obtain elite germplasm. However, current transformation protocols in melons are inefficient and highly genotype-dependent. To improve transformation in melon, we tested different infiltration methods for Agrobacterium-mediated transformation. Among these methods, micro-brushing and sonication for 20 s, followed by vacuum infiltration at −1.0 kPa for 90 s, resulted in the strongest green fluorescent protein signal and increased the proportion of infected explants. We transformed melon with developmental regulatory genes AtGRF5, AtPLT5, AtBBM, AtWUS, AtWOX5, and AtWIND1 from Arabidopsis and estimated regeneration frequencies as the number of regenerating shoots/total number of inoculated explants in the selection medium. The overexpression of AtGRF5 and AtPLT5 in melon resulted in transformation efficiencies of 42.3% and 33% in ZHF and 45.6% and 32.9% in Z12, respectively, which were significantly higher than those of the control. AtGRF5 and AtPLT5 expression cassettes were added to CRISPR/Cas9 genome-editing vectors to obtain transgenic phytoene desaturase CmPDS knockout mutants. Using AtGRF5 or AtPLT5, multi-allelic mutations were observed at CmPDS target sites in recalcitrant melon genotypes. This strategy enables genotype-flexible transformation and promotes precise genome modification technologies in melons.
1. Introduction
The family Cucurbitaceae includes numerous economically important vegetable and fruit species, among which melons, squash, watermelons, and cucumbers are the most widely cultivated. However, there remains potential for improvements in yield, quality, and resistance to abiotic and biotic stress by agricultural breeding and biotechnological strategies [1]. In particular, clustered regularly interspaced short palindromic repeats (CRISPR)/CRISPR-associated nuclease 9 (Cas9) technology is a powerful approach for achieving breeding goals [2]. However, its application depends on a robust and universal method of delivering CRISPR/Cas9 reagents into plant cells [3]. Agrobacterium- and biolistic-mediated transformation are the most widely used delivery methods for generating transgenic plants. Agrobacterium-mediated transformation remains the top choice to produce genome-edited germplasm in crops owing to its cost-effectiveness and capacity to transfer large DNA fragments into chromosomes. Although successful transformation and genome-editing methods have enabled rapid improvements in yield, quality, and resistance in recent years [4,5,6], further expansion of the universal transformation of recalcitrant species or genotypes remains an obstacle [7]. Complete plant regeneration from one or more plant cells via somatic embryogenesis and organogenesis is a particularly challenging step. Organogenesis refers to the direct or indirect organ generation from cultured explants. In direct organogenesis, new organs are formed directly from explant tissues; by contrast, in indirect organogenesis, organs are induced de novo from intermediate tissues, such as the callus, and undergo gradual dedifferentiation [8,9,10]. For horticultural crops, both organogenesis routes are possible. Direct generation is advantageous because it can prevent spontaneous mutations and yield regenerated plants within a shorter time frame [10]. In melon, the initial target cells capable of producing the meristem or whole plantlets are present in the deeper layers of vascular tissue, including the procambium and cambium [6,11]. During direct organogenesis, adventitious shoots can originate from the procambial or cambial cells [12]. A critical step towards achieving efficient transformation is the effective infiltration of vascular cells during direct organogenesis. To a certain extent, transformation efficiency can be enhanced by increasing the infection intensity. However, inefficient infiltration and over-infiltration of the cambium cells in the vascular tissue may lead to variable infection rates mainly due to a failure to transform regeneration-competent cells or severe explant damage. Ineffective Agrobacterium infection hinders its widespread application in cucurbitaceous species.
Although organs and whole plantlets can be regenerated from plant cells that are considered totipotent, natural regeneration from somatic cells is not possible for many plant species. In vitro tissue culture of various explants relies on the application of plant hormone combinations (mainly auxins and cytokinins) to enriched media to enable plantlet regeneration [13]. Establishing a successful de novo organogenesis or transformation protocol often requires customising the cytokinin-to-auxin ratio and other culture factors for each genotype. Understanding plant regeneration mechanisms is crucial for transformation, especially for species or genotypes recalcitrant to transformation. A significant breakthrough for genotype-flexible transformation would be the application of specific morphogenic factors to reprogram somatic cells to induce shoot or somatic embryogenesis [10]. This has sparked new interest in exploiting specific developmental regulators (DRs) for plant transformation. These factors include plant-specific transcription factors, such as the AP2/ERF-family transcription factor BABY BOOM (BBM) [14], shoot apical meristem identity regulator WUSCHEL (WUS) [15,16], WUSCHEL-related homeobox (WOX) [17], GROWTH-REGULATING FACTOR 4 (GRF4) [18], WOUND-INDUCED DEDIFFERENTIATION 1 (WIND1) [19], and AP2-family transcription factor PLETHORA (PLT) [20]. Moreover, they can promote growth and regeneration. The overexpression of GRF4 and the GRF-INTERACTING FACTOR 1 chimera was optimal for increasing the number of transformable crop species, including wheat, triticale, rice, and citrus [21].
In this study, we tested micro-brushing, sonication, and vacuum infiltration with different pressures to obtain optimised parameters for infiltration. To test the effects of DRs on melon transformation, we applied several DRs from Arabidopsis to the melon shoot regeneration process. In addition, we tested the co-expression of DRs using the CRISPR/Cas9 vector to establish an efficient method for obtaining gene-edited plants.
2. Materials and Methods
2.1. Vector Construction
For genetic transformation using the optimal infiltration strategy, a DNA fragment containing the CaMV35S promoter, CpYGFP_eYGFPuv (GenBank: LC217533.1) [22] coding sequence, and At5g59720 terminator were synthesised and introduced into the pCAMBIA1300 vector digested with HindIII and EcoRI, designed as a PV16 vector (Figure S1). To construct expression vectors with DRs, DNA fragments containing the coding sequences for AtGRF5 (At3G13960), AtPLT5 (At5g57390), AtBBM (At5g17430), AtWUS (At2g17950), AtWOX5 (At3g11260), and AtWIND1 (At1g78080) were amplified from the cDNA of Arabidopsis thaliana and confirmed via Sanger sequencing. The DR expression cassette was amplified with the primer pair and inserted into the region between the NcoI and BamHI enzyme sites in the PFGC5941 vector.
As previously described, sgRNA was inserted into the pB7_CAS9_TPC vector to obtain the genome-editing vector [23]. The binary vectors pB7_CAS9_TPC and pBS_KSgRNA were obtained from Dr. Bin Liu from the Hami-melon Research Center, Xinjiang Academy of Agricultural Sciences in China. For the assembly of the two gRNAs into pB7_CAS9_TPC, a four-primer mixture with T1-F0-PDS/T2-R0-PDS and T1-BsF-pds/T2-BsR-pds at a 1:20 ratio was used for polymerase chain reaction (PCR) amplification, along with pBS_KSgRNA and Phanta Max Super-Fidelity DNA Polymerase (Vazyme, Nanjing, China), following the manufacturer’s recommendations. PCR was conducted at 95 °C for 3 min, followed by 35 cycles of 95 °C for 15 s, 60 °C for 30 s, and 68 °C for 5 min. The T1T2 PCR product was separated on a 1.5% agarose gel and purified using a Gel Extraction Kit D2500 (OMEGA, Biel, Switzerland), according to the manufacturer’s instructions. The T1T2 PCR product was assembled into pB7_CAS9_TPC using the Golden Gate cloning method with BsaI-HFv2 and T4 ligase (NEB, Ipswich, MA, USA) [23]. A CRISPR/Cas9 vector was constructed and named pB7-CmPDS. The AtGRF5 or AtPLT5 expression cassettes were amplified from the pAtGRF5 and pAtPLT5 vector and inserted into the PmeI site of pB7-CmPDS to generate pB7-PDSw1 and pB7-PDSw2, respectively. Binary vectors were used to transform 5-α competent Escherichia coli. Positive cloning was confirmed using Sanger sequencing. Plasmids were isolated using the EZNA Plasmid Mini Kit (OMEGA) and transformed into Agrobacterium tumefaciens EHA105. All of the primers used are listed in Table S1.
2.2. Agrobacterium-Mediated Melon Transformation
After removing the coats with a scalpel and forceps, seeds were surface-sterilised with 75% ethanol for 30 s (Figure S2). The peeled seeds were sterilised for 10 min with 2% sodium hypochlorite solution and then rinsed 4–5 times with sterile distilled water. Sterilised seeds were spread on Petri dishes containing germination medium at 28 °C in the dark for 24–36 h. Two days before transformation, an Agrobacterium stock solution (EHA105) carrying the expression vectors was cultured in 5 mL of liquid LB medium with 50 mg/L spectinomycin and 25 mg/L rifampicin for 16–18 h at 28 °C with gentle shaking. Starter cultures were transferred to 30 mL of liquid LB medium at a 1:1000 ratio and cultured overnight to an OD600 of 0.4–0.5. The Agrobacterium culture was centrifuged at 3000 rpm and resuspended to an OD600 of 0.2 with inoculation medium at 25 °C. The cotyledons were cut transversely in half, and the distal segments were removed. The proximal end of the cotyledon exhibited a U-shaped cut after removing the hypocotyl and was used as an explant for the following treatments: scratching with a micro-brush (KITA, Nanotek Brush NANO-3-003, Tokyo, Japan) near the end with the U-shaped cut, sonication using an ultrasonic cleaning instrument for 20 s, and vacuum treatment with the Agrobacterium suspension. For vacuum infiltration, wounded explants were placed in a 150 mL triangular glass bottle containing 30 mL of the Agrobacterium inoculum. Vacuum infiltration was applied for 90 s at −0.3, −0.5, or −1.0 kPa in a sterile desiccator (Fujiwara oil-free vacuum V-1500, Taizhou, China). The vacuum was released gently and slowly to avoid physical damage to the explants. After removing the excess Agrobacterium suspension from the surface of the explants using sterilised filter paper, infected explants were cultured in the dark in a cocultivation medium for 2 d. The explants were rinsed thrice with sterile water containing 200 mg/L timentin and then transferred to the selection medium. When explants were cultured in the selection medium for 3 d, the green fluorescent protein (GFP) intensity was measured. The explants were cultured in the selection medium for 3–4 weeks to determine the transformation effect. The green shoots regenerated from SM with 4 mg/L glufosinate-ammonium were excised and transferred to jars containing a root induction medium. The detailed compositions and sources of each tissue culture medium are listed in Supplementary File S1.
2.3. Detection and Calculation of GFP Intensity
To estimate the GFP expression level in explants after cocultivation, a fluorescence microscope was used to capture images. These images were evaluated using ImageJ. A single channel was extracted by selecting the “Image-Color-Split Channels” option. The threshold was adjusted and the appropriate area was selected by choosing the “Image-Adjust-Threshold” option. To avoid errors caused by manually selecting threshold values for different images, the default threshold value was used. Note that if the image contains a scale, the threshold may need to be adjusted or the scale area may need to be removed by selecting “Edit-Fill” to avoid any potential impact on the final results. Red colour was used to mark the selected area, and “Dark Background” was selected for the background of fluorescence images. In the Auto Threshold interface, an appropriate threshold was chosen by selecting ”Image-Adjust-Auto Threshold”. “Try all” was selected in this step, and a list of all thresholds set by the algorithm was obtained by clicking “OK”. Based on the results, the “Default” algorithm was selected and parameters for measurement were set (Analyze-Set Measurements). Parameters were adjusted by selecting the mean grey value and limit to threshold under Analyze-Set Measurements. Finally, detection was accomplished by selecting the Analyze-Measure and clicking “Measure”. Mean values are the average fluorescence intensity, equal to the sum of fluorescence intensity/defined area.
2.4. High-Throughput Tracking of Mutations (Hi-TOM) Sequencing
Hi-TOM sequencing was used to determine the editing efficiency of the target genes in positive plants [24]. First-round PCR was performed using site-specific primers with bridging sequences of 5′-GGAGTGAGTACGGTGTGC-3′ for the forward primer and 5′-GAGTTGGATGCTGGATGG-3′ for the reverse primer at the 5′ end (Table S1). The 10 μL reaction mix contained 50 ng of genomic DNA, 0.5 μM specific primers, and 5.0 μL of Go TaqGreen Master Mix (2×) (Vazyme). The second round of PCR to amplify 1 μL of the primary PCR product was conducted in a volume of 20 μL with a pair of markers, and 4-bp barcode tags were added to the 5′ end of the primers separately for each sample. The DNA products from the secondary amplification were sequenced using an Illumina sequencer, and the sequencing data were analysed using the Hi-TOM website (http://www.hi-tom.net/hi-tom/). The editing efficiency was calculated as the ratio of mutant reads to the total number of reads at the target site. Additionally, sequencing data were analysed to determine the types of mutations induced at the target site, such as insertions, deletions, or substitutions (Table S2).
3. Results
3.1. Optimal Strategy for Genetic Transformation in Melon
Stable and highly efficient regeneration via organogenesis or somatic embryogenesis is the basis of successful genetic transformation [25]. We first tested the genetic transformation of the melon cultivars ZHF—the female parental line of the cultivar ‘XueMi’ (Cucumis melo var. saccharinus)—and Z12—the female parental line of the cultivar ‘Wunongqingyu’ (Cucumis melo L. var. chinensis Pangalo)—both of which are relatively recalcitrant to transformation. A GFP-based system was used to evaluate the effect of vacuum infiltration on the vascular tissue from deep layers of melon cotyledon explants. To improve the infection intensity, we used sonication and micro-brush treatments as well as different vacuum infiltration pressures to estimate the infection rate. Explants were exposed to three treatments: micro-brushing, sonication, and vacuum infiltration (−0.3, −0.5, and −1.0 kPa). Low GFP fluorescence in the infected explants was observed without vacuum infiltration. A combination of micro-brushing, sonication, and vacuum infiltration at different intensities resulted in elevated GFP abundance. Compared with those in controls, explants exposed to −1.0 kPa infiltration showed a higher GFP fluorescence intensity and an increase in the proportion of explants with infected vascular tissue (Figure 1a). Although the combination of micro-brushing, sonication, and vacuum infiltration increased the infection rate, partial explants exhibited severe tissue disruption and died 2–3 d after infection in the SM. As the vacuum infiltration intensity increased, the survival rate of explants decreased gradually (Figure 1b, Tables S3 and S4). Living transformed explants were cultured in a shoot-inducing medium containing 4 mg/L Basta for 2–3 weeks. The regeneration rate of transformed explants was significantly greater under −0.5 and −1.0 kPa than in the controls (Figure 1c). To evaluate the effect of the infiltration intensity on transformation efficiency, we divided the number of GFP-positive T0 plants by the number of infected explants. The transformation efficiencies for ZHF and Z12 were 42.2% and 32.5%, respectively, after treatment D (micro-brushing, 30 s sonication, and vacuum infiltration at −1.0 kPa); these values were substantially higher than that of the control (Table 1). Overall, the transformation efficiency was significantly improved when the infected explants were subjected to a combined treatment of micro-brushing, 30 s sonication, and vacuum infiltration at −1.0 kPa.


Figure 1.
Infection of melons using different treatment approaches. (a) Green fluorescent protein (GFP) intensity, (b) survival rate, and (c) regeneration rate of explants with infected explant from ZHF and Z12 melon cultivars under four different treatments. Treatment A: micro-brushing (Brush) + sonication (Son) (30 s); treatment B: Brush + Son (30 s) + vacuum (−0.3 kPa); treatment C: Brush + Son (30 s) + vacuum (−0.5 kPa); treatment D: Brush + Son (30 s) + vacuum (−1.0 kPa). CK: transgenic explants without treatment. The number of explants is the sum of the surviving explants after infection in three independent experiments. Data are presented as the mean of three independent replicates, and error bars indicate standard deviations. Different lowercase letters indicate significant differences (p < 0.1, Tukey’s test). (d) GFP-fluorescent explant images were captured using a fluorescence camera. Bar = 10 mm.

Table 1.
Transformation efficiency of ZHF and Z12 cultivars subjected to different treatments.
3.2. Overexpression of DRs Promotes Shoot Organogenesis and Increases Melon Transformation Efficiency
Somatic embryogenesis involves complex cellular reprogramming and the activation of various signalling pathways. Several molecular genetic studies have suggested that the ectopic expression of transcription factor genes induces spontaneous somatic embryogenesis. Transcription factor genes, key regulators of plant cell totipotency, are ectopically expressed and induce somatic embryogenesis without requiring exogenous plant growth regulators or stress [26,27]. Furthermore, the ectopic expression of DR genes stimulates signalling pathways that promote cell proliferation and morphogenesis during embryogenesis [17,21,25,28,29,30,31,32]. Although shoot induction directly from cotyledons via organogenesis occurs at high rates in melons, transformed cells are usually concentrated 2–3 mm away from the cut sides, where shoot formation is rare. To test the effects of DRs on melon transformation via organogenesis, we cloned several Arabidopsis DRs reported to enhance cell division and embryogenesis in other species (Figure 2a). As melon transformation is highly genotype-dependent, we overexpressed these DRs individually in two melon cultivars (ZHF and Z12) and investigated the effects on the transformation efficiency. These two lines showed enhanced transformability when AtGRF5 and AtPLT5 constructs were used in the medium with or without hormone combinations (Figure 2b). ZHF and Z12 showed average transformation efficiencies with the control construct of 1.1% and 2.2% in the MS medium without hormones and 3.7% and 4.8% in the medium with hormone combinations, respectively. By contrast, introducing the 35S: AtGRF5/AtPLT5/AtBBM/AtWUS/AtWOX5/AtWIND1 constructs into the explants resulted in higher transformation efficiencies than those of the control experiment in both treatments (no hormones and the combination of 6BA and ABA). The overexpression of AtGRF5 and AtPLT5 in ZHF resulted in transformation efficiencies of 20.3% and 16% in hormone-free medium and 42.3% and 33% in medium with 6BA and ABA. In Z12, the overexpression of AtGRF5 and AtPLT5 resulted in transformation efficiencies of 26.1% and 11%, respectively, in hormone-free medium and 45.6% and 32.9% in medium containing 6BA and ABA. Transgenic explants containing the AtGRF5 and AtPLT5 overexpression cassettes produced more positive shoots in co-transformation experiments, suggesting that AtGRF5 and AtPLT5 improve transgenic event recovery. In addition, shoot formation capacity was higher using hormone combinations compared to non-hormone cultures. The transformation of AtBBM/AtWUS/AtWOX5/AtWIND1 in melon explants resulted in increased transformation efficiency, although the differences were not statistically significant (Figure 2b,c).

Figure 2.
Effects of developmental regulators (DRs) on melon transformation. (a) Schematic diagram of constructs with DRs used in this study. (b) Transformation efficiencies of ZHF and Z12 melons were obtained using the indicated constructs in individual media with or without hormone combinations (6-benzylaminopurine (6BA) + abscisic acid (ABA)). Positive transformation events were defined as explants showing at least one regenerated adventitious bud expressing Basta species. Different lowercase letters indicate significant differences (p < 0.1, Tukey’s test). (c) Explants with shoot induction on selection medium with 6BA and ABA at the plant transformation stage with different DRs in ZHF and Z12, Bar = 10 mm.
3.3. Application of AtGRF5 and AtPLT5 to the CRISPR/Cas9 System
Targeted mutagenesis using the CRISPR/Cas9 system is an effective breeding technology that can produce desired mutations in the target gene. In this experiment, we tested the compatibility of AtGRF5- and AtPLT5-mediated transformations using genome-editing tools in melon. AtGRF5 and AtPLT5 driven by CaMV35Sp were inserted into the CRISPR/Cas9 genome-editing plasmid pB7-CAS9-TPC [23], generating pB7-PDSw1 and pB7-PDSw2, respectively (Figure 3a). Two previously designed spacers (sgRNA1 and sgRNA2) targeting the melon phytoene desaturase gene Cucumis melo (CmPDS) were selected [33]. We added the effective DRs AtGRF5 and AtPLT5 to CRISPR/Cas9 genome-editing vectors. We obtained transgenic plants with a knockout of CmPDS and the reference MELO3C017772.2 in the International Cucurbit Genomics Initiative database. The resulting gene-edited vector plasmids were used to transform cotyledon explants. Upon co-expressing AtGRF5 and AtPLT5, we obtained nine and five CmPDS mutants in the ZHF and Z12 transgenic plants, respectively. To determine the mutations introduced by the CRISPR/Cas9 system in T0 plants, we amplified the PCR products overlapping the target sequence for melon T0 plants. We analysed these by Hi-TOM. Each T0 plant harboured multiple mutations based on the Hi-TOM sequencing data. Plants with an editing ratio at the target site (the number of reads with target mutations divided by the total number of reads for the target site) of >10% were considered ‘edited’. Sequencing data revealed that the editing frequency at the two loci ranged from 12.5% to 33.3% in the 14 independent T0-edited melon plants (Figure 3b). The mutations in T0 plants included a 1- to 6-bp deletion or a 2-bp insertion (Figure 3c). After CRISPR/Cas9-mediated phytoene desaturase gene (PDS) knockout, some cotyledons regenerated albino shoots. By contrast, others regenerated green shoots and exhibited mosaicism or regenerated secondary albino shoots. Complete albino plants were transferred to the propagation medium (Figure 3d).


Figure 3.
Developmental regulators (DRs) facilitate the CRISPR/Cas9-mediated genome editing of CmPDS. (a) Schematic diagrams of the CRISPR/Cas9 vector with DRs. (b,c). Mutation types at two target sites in CmPDS from ZHF and Z12 transformed with the AtGRF5- and AtPLT5-mediated CRISPR/Cas9 system. “D” indicates a deletion; ”I” indicates an insertion. The number indicates the length of each mutation type (bp). The PAM sequences for the two target sites are highlighted in red. (d) Phenotype of the regenerated CRISPR/Cas9-mutated plants. ZHF-cmpds and Z12-cmpds show fully albino plants regenerated from individual transformation. CmPDS shoots regenerated from transformed explants. When CmPDS shoots were transferred to the rooting medium, PDS disruption resulted in seedlings with photobleached or white leaves. Bars = 10 mm.
4. Discussion
Plant genetic transformation is a complex process. Numerous factors, including tissue culture conditions, transformation methods, selection process, genetic factors, and environmental conditions, affect the regeneration successes of positive or gene-edited plants. Among these challenges, the low efficiency of genetic transformation methods and the adaptability of species or genotypes to the Agrobacterium-mediated transformation system are important factors that determine the application of transgenic and gene-editing approaches. The infection of target regeneration-competent tissues with Agrobacterium is a key step in stable genetic transformation. In melon transformation, adventitious shoots derived from the target are initiated from the procambium or cambium cells during organogenesis. To improve the infection of the deeper cell layers of explants, we used combinations of micro-brushing, sonication, and vacuum infiltration to ensure absolute infection of cambium cells in the vascular tissue. After the adjustment of infiltration parameters, we ensured the sufficient infection of melon explant cells without excessive Agrobacterium growth. In a previous study, vacuum infiltration was applied with a syringe, relying on complicated manual operation [6], the number of explants treated at each time point was limited, and the chance of bacterial contamination was high. In our study, explants in sterile containers were conveniently treated by vacuum infiltration at −1.0 kPa to improve the transformation efficiency.
The genotype dependence in melon transformation implies that genetic transformation can only be achieved in a few varieties [34]. DR-assisted methods are the most robust and widely applicable strategy for overcoming this genotypic dependence. Numerous individual DRs or DR combinations have been used to induce shoot and somatic embryogenesis in various species [35]. Growth-regulating factors are plant-specific transcription factors with varying numbers of paralogues in plant species. GRF5 promotes organogenesis in dicot species [29]. BBM and WUS promote direct somatic embryogenesis and enhance Agrobacterium-mediated transformation during ectopic expression in monocot species [30]. To avoid pleiotropic deleterious effects of the constitutive expression of BBM and WUS during plant growth, strategies to express these loci under the control of a tissue-specific or auxin-inducible promoter can be used to initiate DR expression during a specific stage. Furthermore, these DR cassettes can also be entirely removed from the expression vector at the post-infection stage [36]. WOX5, which is expressed in the quiescent centre, is essential for shoot/root apical and stem-cell maintenance in flowering plants [37]. Arabidopsis PLT5 can improve the in-planta transformation efficiency in snapdragon (Antirrhinum majus) and tomato (Solanum lycopersicum), likely via auxin and cytokinin biosynthesis. PLT5 overexpression reportedly allows for the tissue culture-based transformation of recalcitrant genotypes in sweet peppers [38]. In addition to hormone-induced de novo regeneration, wounds are a primary trigger of organ regeneration. The AP2/ERF transcription factor WIND1 promotes cell dedifferentiation and proliferation during callus formation at wound sites. The overexpression of WIND1 and its homologues stimulates callus formation and shoot regeneration. In the present study, we observed that the frequency of explants containing transgenic shoots increased significantly when AtGRF5 was transformed into melons. Although GRF overexpression improved transgenic cell proliferation in other crops, such as canola, soybean, and sunflower, the transformation efficiency did not always increase [29]. Target explants and phytohormones for regeneration may interact with the overexpressed AtGRF5, which increases the sensitivity of melon explants to cytokinins and stimulates shoot regeneration when co-expressed with cytokinin catabolic enzymes. After transformation, PLT5 overexpression stimulates callus formation and shoot regeneration at the wound site. PLT5 functions in acquiring cellular pluripotency, preceding shoot progenitor establishment via WIND1 and WUS, which explains its strong effect on genetic transformation. Cellular dedifferentiation, reflected by callus formation, re-differentiation, and de novo shoot regeneration from calli, is critical for successful gene delivery into plant cells. Despite the improvements using DRs, challenges persist in developing reliable transformation systems in recalcitrant melon species or genotypes not mentioned herein. If these DRs function hierarchically during embryogenesis and callus formation, the DRs can be combined in an additive manner to improve regeneration efficiency. Constitutively expressed DRs may have undesired pleiotropic effects, such as severe growth defects and infertility [35]. Although we did not obtain similar results in our transgenic plants, strategies to induce expression during a specific stage and the use of temporal and spatial promoters to drive expression, with the removal of the expression cassette after infection under specific culture conditions, can avoid aberrant vegetative or reproductive growth. This method can eliminate pleiotropic effects by self-pollination or crossbreeding of genome-edited plants. Although different regeneration efficiencies can be obtained upon using various DRs, developmental plasticity is based on a combination of factors, including hormone interactions, cell cycle progression, nutrient metabolism, and injury-induced reactive oxygen species (ROS) at the wound site. We observed that overexpressing six DRs could increase the transformation efficiency with the 6BA + ABA combination over that without these hormones, indicating that the type and concentration of hormones added to the culture medium also affect genetic transformation. AtGRF5 or AtPLT5 had greater effects on the transformation efficiency than those of other DRs, and this could be explained by their roles in phytohormonal crosstalk, ROS homeostasis, cell cycle progression, and cell division in the overexpressing plants.
In our experiment, we used DR expression cassettes in the CRISPR/Cas9 genome editing system to obtain gene-edited melon plants. Although DRs can improve the transformation efficiency, the incidence of targeted mutations is determined by the expression levels of the sgRNAs and Cas9 nuclease. The widely used Arabidopsis U3 and U6 promoter and rice U6 promoter exhibit high activity in monocot and dicot plants. The application of crop codon-optimised Cas9 resulted in high mutagenesis efficiency [39]. Many endogenous Pol II and Pol III promoters, especially in fruit crops, have been discovered for the optimisation of the CRISPR/Cas9 system [39,40]. Multiple tRNA-gRNA units expressed under the control of an endogenous Pol III promoter can produce simultaneous mutations at multiple targeted genomic loci and enable a higher editing efficiency than that of the simplex editing system [41]. Additionally, improved sequence selection of gRNA spacers to generate DSBs or two nearby gRNAs generally increases the editing efficiency over that obtained by the expression of a single gRNA [42]. To develop effective and robust melon genome-editing systems, endogenous pol II and pol III promoters from melon and multi-sgRNA/Cas9 systems could be used to expand the toolbox and facilitate the application of CRISPR/Cas9 technology to obtain new germplasm resources with desirable agronomic traits.
5. Conclusions
We demonstrated that optimised infiltration manipulation can improve Agrobacterium transformation into melon explant cells. Strategies for enhancing melon transformation are moving beyond culture media and conditions. Understanding the molecular mechanisms by which key regulators contribute to the reprogramming, pluripotency acquisition, and regeneration of somatic cells can aid in identifying DRs required for transforming recalcitrant species or genotypes. AtGRF5 and AtPLT5 overexpression notably increased genetic transformation in two melon genotypes with or without phytohormones. These DRs could trigger somatic cell embryogenesis to accomplish efficient regeneration and transformation. Finally, with the assistance of DRs in the CRISPR/Cas9 system, gene editing was reasonably effective in melons, laying the foundation for genome editing for stable transformation. The combination of optimised infiltration manipulation, DR gene expression, and the Cas9 system offers a promising approach for accelerating genome editing in genotype-flexible transformation.
Supplementary Materials
The following supporting information can be downloaded at: https://www.mdpi.com/article/10.3390/genes14071432/s1, Figure S1: The CpYGFP_eYGFPuv expression cassette in binary vector PV16; Figure S2: Explant preparation; Table S1: Primers used in this study; Table S2: Mutation types determined by Hi-TOM; Table S3: Survival rate of the melon variety ZHF after Treatments A, B, C, and D; Table S4: Survival rate of melon variety Z12 after Treatments A, B, C, and D; Supplemental File S1: Tissue culture medium.
Author Contributions
Conceptualisation, L.W. and Z.W.; writing—original draft preparation, L.W.; regeneration methodology, H.Z.; formal analysis, Z.W.; planting material acquisition, J.R. and N.Z.; writing—review and editing, T.M., X.Z. and Y.S. All authors have read and agreed to the published version of the manuscript.
Funding
This research was funded by Hubei Key Research Project of CRISPR Gene-Editing Technology in Fruit Vegetable Crops, grant number 2022BBA0062; Wuhan Major Project of Key Technologies in Biological Breeding and New Variety Cultivation, grant number 2022021302024852; Wuhan applied basic frontier Project, grant number 2020020601012296; and Tianshan Innovation Team Plan Project in The People’s Government of Xinjiang Uygur Autonomous Region of China, grant number 2022D14015.
Institutional Review Board Statement
Not applicable.
Informed Consent Statement
Not applicable.
Data Availability Statement
Data are contained in the paper or Supplementary Files.
Acknowledgments
We thank Bin Liu from Xinjiang Academy of Agricultural Sciences for providing the CRISPR/Cas9 vector and also for his contributions to the optimisation of the melon genetic transformation system.
Conflicts of Interest
The authors declare no conflict of interest.
References
- Ma, L.; Wang, Q.; Zheng, Y.; Guo, J.; Yuan, S.; Fu, A.; Bai, C.; Zhao, X.; Zheng, S.; Wen, C.; et al. Cucurbitaceae genome evolution, gene function, and molecular breeding. Hortic. Res. 2022, 9, uhab057. [Google Scholar] [CrossRef] [PubMed]
- Bhatta, B.P.; Malla, S. Improving horticultural crops via Crispr/Cas9: Current successes and prospects. Plants 2020, 9, 1360. [Google Scholar] [CrossRef] [PubMed]
- Zhu, H.; Li, C.; Gao, C. Applications of Crispr-Cas in agriculture and plant biotechnology. Nat. Rev. Mol. Cell Biol. 2020, 21, 661–677. [Google Scholar] [CrossRef] [PubMed]
- Feng, Q.; Xiao, L.; He, Y.; Liu, M.; Wang, J.; Tian, S.; Zhang, X.; Yuan, L. Highly efficient and genotype-independent genetic transformation and gene editing in watermelon (Citrullus lanatus) by utilizing a chimeric Clgrf4-Gif1 gene. J. Integr. Plant Biol. 2021, 63, 2038–2042. [Google Scholar] [CrossRef]
- Pan, W.; Cheng, Z.; Han, Z.; Yang, H.; Zhang, W.; Zhang, H. Efficient genetic transformation and Crispr/Cas9-mediated genome editing of watermelon assisted by genes encoding developmental regulators. J. Zhejiang Univ. Sci. B 2022, 23, 339–344. [Google Scholar] [CrossRef]
- Xin, T.; Tian, H.; Ma, Y.; Wang, S.; Yang, L.; Li, X.; Zhang, M.; Chen, C.; Wang, H.; Li, H.; et al. Targeted creating new mutants with compact plant architecture using Crispr/Cas9 genome editing by an optimized genetic transformation procedure in cucurbit plants. Hortic. Res. 2022, 9, uhab086. [Google Scholar] [CrossRef]
- Nanasato, Y.; Tabei, Y. A method of transformation and current progress in transgenic research on cucumbers and Cucurbita species. Plant Biotechnol. 2020, 37, 141–146. [Google Scholar] [CrossRef]
- Hussain, A.; Ahmed, I.; Nazir, H.; Ullah, I. Plant tissue culture: Current status and opportunities. In Recent Advances in Plant In Vitro Culture; Leva, A., Rinaldi, L., Eds.; Delve Publishing: Burlington, ON, Canada, 2012. [Google Scholar]
- Sang, Y.L.; Cheng, Z.J.; Zhang, X.S. Plant stem cells and de novo organogenesis. New Phytol. 2018, 218, 1334–1339. [Google Scholar] [CrossRef]
- Shin, J.; Bae, S.; Seo, P.J. De novo shoot organogenesis during plant regeneration. J. Exp. Bot. 2020, 71, 63–72. [Google Scholar] [CrossRef]
- Nanasato, Y.; Okuzaki, A.; Tabei, Y. Improving the transformation efficiency of Cucurbita species: Factors and Strategy for Practical Application. Plant Biotechnol. 2013, 30, 287–294. [Google Scholar] [CrossRef]
- Xu, L.; Huang, H. Genetic and epigenetic controls of plant regeneration. Curr. Top. Dev. Biol. 2014, 108, 1–33. [Google Scholar] [CrossRef] [PubMed]
- Sugiyama, M. Historical review of research on plant cell dedifferentiation. J. Plant Res. 2015, 128, 349–359. [Google Scholar] [CrossRef]
- Boutilier, K.; Offringa, R.; Sharma, V.K.; Kieft, H.; Ouellet, T.; Zhang, L.; Hattori, J.; Liu, C.M.; van Lammeren, A.A.; Miki, B.L.; et al. Ectopic expression of baby boom triggers a conversion from vegetative to embryonic growth. Plant Cell 2002, 14, 1737–1749. [Google Scholar] [CrossRef] [PubMed]
- Somssich, M.; Je, B.I.; Simon, R.; Jackson, D. Clavata-Wuschel signaling in the shoot meristem. Development 2016, 143, 3238–3248. [Google Scholar] [CrossRef] [PubMed]
- Zuo, J.; Niu, Q.W.; Frugis, G.; Chua, N.H. The Wuschel gene promotes vegetative-to-embryonic transition in Arabidopsis. Plant J. 2002, 30, 349–359. [Google Scholar] [CrossRef] [PubMed]
- Wang, K.; Shi, L.; Liang, X.; Zhao, P.; Wang, W.; Liu, J.; Chang, Y.; Hiei, Y.; Yanagihara, C.; Du, L.; et al. The gene Tawox5 overcomes genotype dependency in wheat genetic transformation. Nat. Plants 2022, 8, 110–117. [Google Scholar] [CrossRef]
- Omidbakhshfard, M.A.; Proost, S.; Fujikura, U.; Mueller-Roeber, B. Growth-regulating factors (Grfs): A small transcription factor family with important functions in plant biology. Mol. Plant 2015, 8, 998–1010. [Google Scholar] [CrossRef]
- Iwase, A.; Mita, K.; Nonaka, S.; Ikeuchi, M.; Koizuka, C.; Ohnuma, M.; Ezura, H.; Imamura, J.; Sugimoto, K. Wind1-based acquisition of regeneration competency in Arabidopsis and rapeseed. J. Plant Res. 2015, 128, 389–397. [Google Scholar] [CrossRef]
- Kareem, A.; Durgaprasad, K.; Sugimoto, K.; Du, Y.; Pulianmackal, A.J.; Trivedi, Z.B.; Abhayadev, P.V.; Pinon, V.; Meyerowitz, E.M.; Scheres, B.; et al. Plethora genes control regeneration by a two-step mechanism. Curr. Biol. 2015, 25, 1017–1030. [Google Scholar] [CrossRef]
- Debernardi, J.M.; Tricoli, D.M.; Ercoli, M.F.; Hayta, S.; Ronald, P.; Palatnik, J.F.; Dubcovsky, J. A Grf-Gif chimeric protein improves the regeneration efficiency of transgenic plants. Nat. Biotechnol. 2020, 38, 1274–1279. [Google Scholar] [CrossRef]
- Chin, D.P.; Shiratori, I.; Shimizu, A.; Kato, K.; Mii, M.; Waga, I. Generation of brilliant green fluorescent petunia plants by using a new and potent fluorescent protein transgene. Sci. Rep. 2018, 8, 16556. [Google Scholar] [CrossRef] [PubMed]
- Liu, B.; Santo Domingo, M.; Mayobre, C.; Martín-Hernández, A.M.; Pujol, M.; Garcia-Mas, J. Knock-out of Cmnac-nor affects melon climacteric fruit ripening. Front. Plant Sci. 2022, 13, 1–11. [Google Scholar] [CrossRef] [PubMed]
- Liu, Q.; Wang, C.; Jiao, X.; Zhang, H.; Song, L.; Li, Y.; Gao, C.; Wang, K. Hi-Tom: A platform for high-throughput tracking of mutations induced by Crispr/Cas systems. Sci. China Life Sci. 2019, 62, 1–7. [Google Scholar] [CrossRef] [PubMed]
- Lee, K.; Wang, K. Strategies for genotype-flexible plant transformation. Curr. Opin. Biotechnol. 2023, 79, 102848. [Google Scholar] [CrossRef]
- Horstman, A.; Bemer, M.; Boutilier, K. A transcriptional view on somatic embryogenesis. Regeneration 2017, 4, 201–216. [Google Scholar] [CrossRef] [PubMed]
- Horstman, A.; Li, M.; Heidmann, I.; Weemen, M.; Chen, B.; Muino, J.M.; Angenent, G.C.; Boutilier, K. The baby boom transcription factor activates the Lec1-Abi3-Fus3-Lec2 network to induce somatic embryogenesis. Plant Physiol. 2017, 175, 848–857. [Google Scholar] [CrossRef] [PubMed]
- Che, P.; Wu, E.; Simon, M.K.; Anand, A.; Lowe, K.; Gao, H.; Sigmund, A.L.; Yang, M.; Albertsen, M.C.; Gordon-Kamm, W.; et al. Wuschel2 enables highly efficient Crispr/Cas-targeted genome editing during rapid de novo shoot regeneration in sorghum. Commun. Biol. 2022, 5, 344. [Google Scholar] [CrossRef] [PubMed]
- Kong, J.; Martin-Ortigosa, S.; Finer, J.; Orchard, N.; Gunadi, A.; Batts, L.A.; Thakare, D.; Rush, B.; Schmitz, O.; Stuiver, M.; et al. Overexpression of the transcription factor growth-regulating factor5 improves transformation of dicot and monocot species. Front. Plant Sci. 2020, 11, 572319. [Google Scholar] [CrossRef]
- Lowe, K.; Wu, E.; Wang, N.; Hoerster, G.; Hastings, C.; Cho, M.J.; Scelonge, C.; Lenderts, B.; Chamberlin, M.; Cushatt, J.; et al. Morphogenic regulators baby boom and wuschel improve monocot transformation. Plant Cell 2016, 28, 1998–2015. [Google Scholar] [CrossRef]
- Maher, M.F.; Nasti, R.A.; Vollbrecht, M.; Starker, C.G.; Clark, M.D.; Voytas, D.F. Plant gene editing through de novo induction of meristems. Nat. Biotechnol. 2020, 38, 84–89. [Google Scholar] [CrossRef]
- Méndez-Hernández, H.A.; Ledezma-Rodríguez, M.; Avilez-Montalvo, R.N.; Juárez-Gómez, Y.L.; Skeete, A.; Avilez-Montalvo, J.; De-la-Peña, C.; Loyola-Vargas, V.M. Signaling overview of plant somatic embryogenesis. Front. Plant Sci. 2019, 10, 77. [Google Scholar] [CrossRef]
- Hooghvorst, I.; López-Cristoffanini, C.; Nogués, S. Efficient knockout of phytoene desaturase gene using Crispr/Cas9 in melon. Sci. Rep. 2019, 9, 17077. [Google Scholar] [CrossRef] [PubMed]
- Chovelon, V.; Restier, V.; Giovinazzo, N.; Dogimont, C.; Aarrouf, J. Histological study of organogenesis in Cucumis melo L. after genetic transformation: Why is it difficult to obtain transgenic plants? Plant Cell Rep. 2011, 30, 2001–2011. [Google Scholar] [CrossRef] [PubMed]
- Chen, Z.; Debernardi, J.M.; Dubcovsky, J.; Gallavotti, A. Recent advances in crop transformation technologies. Nat. Plants 2022, 8, 1343–1351. [Google Scholar] [CrossRef] [PubMed]
- Hoerster, G.; Wang, N.; Ryan, L.; Wu, E.; Gordon-Kamm, B. Use of non-integrating Zm-Wus2 vectors to enhance maize transformation: Non-integrating Wus2 enhances transformation. Vitr. Cell Dev. Biol. 2020, 56, 265–279. [Google Scholar] [CrossRef]
- Zhang, Y.; Jiao, Y.; Jiao, H.; Zhao, H.; Zhu, Y.X. Two-step functional innovation of the stem-cell factors Wus/Wox5 during plant evolution. Mol. Biol. Evol. 2017, 34, 640–653. [Google Scholar] [CrossRef]
- Lian, Z.; Nguyen, C.D.; Liu, L.; Wang, G.; Chen, J.; Wang, S.; Yi, G.; Wilson, S.; Ozias-Akins, P.; Gong, H.; et al. Application of developmental regulators to improve in planta or in vitro transformation in plants. Plant Biotechnol. J. 2022, 20, 1622–1635. [Google Scholar] [CrossRef]
- Zhang, S.; Wu, S.; Hu, C.; Yang, Q.; Dong, T.; Sheng, O.; Deng, G.; He, W.; Dou, T.; Li, C.; et al. Increased mutation efficiency of Crispr/Cas9 genome editing in banana by optimized construct. PeerJ 2022, 10, e12664. [Google Scholar] [CrossRef]
- Ren, C.; Liu, Y.; Guo, Y.; Duan, W.; Fan, P.; Li, S.; Liang, Z. Optimizing the Crispr/Cas9 system for genome editing in grape by using grape promoters. Hortic. Res. 2021, 8, 52. [Google Scholar] [CrossRef]
- Qi, W.; Zhu, T.; Tian, Z.; Li, C.; Zhang, W.; Song, R. High-efficiency Crispr/Cas9 multiplex gene editing using the glycine tRNA-processing system-based strategy in maize. BMC Biotech. 2016, 16, 58. [Google Scholar] [CrossRef]
- Oh, Y.; Lee, B.; Kim, H.; Kim, S.-G. A multiplex guide RNA expression system and its efficacy for plant genome engineering. Plant Methods 2020, 16, 37. [Google Scholar] [CrossRef] [PubMed]
Disclaimer/Publisher’s Note: The statements, opinions and data contained in all publications are solely those of the individual author(s) and contributor(s) and not of MDPI and/or the editor(s). MDPI and/or the editor(s) disclaim responsibility for any injury to people or property resulting from any ideas, methods, instructions or products referred to in the content. |
© 2023 by the authors. Licensee MDPI, Basel, Switzerland. This article is an open access article distributed under the terms and conditions of the Creative Commons Attribution (CC BY) license (https://creativecommons.org/licenses/by/4.0/).